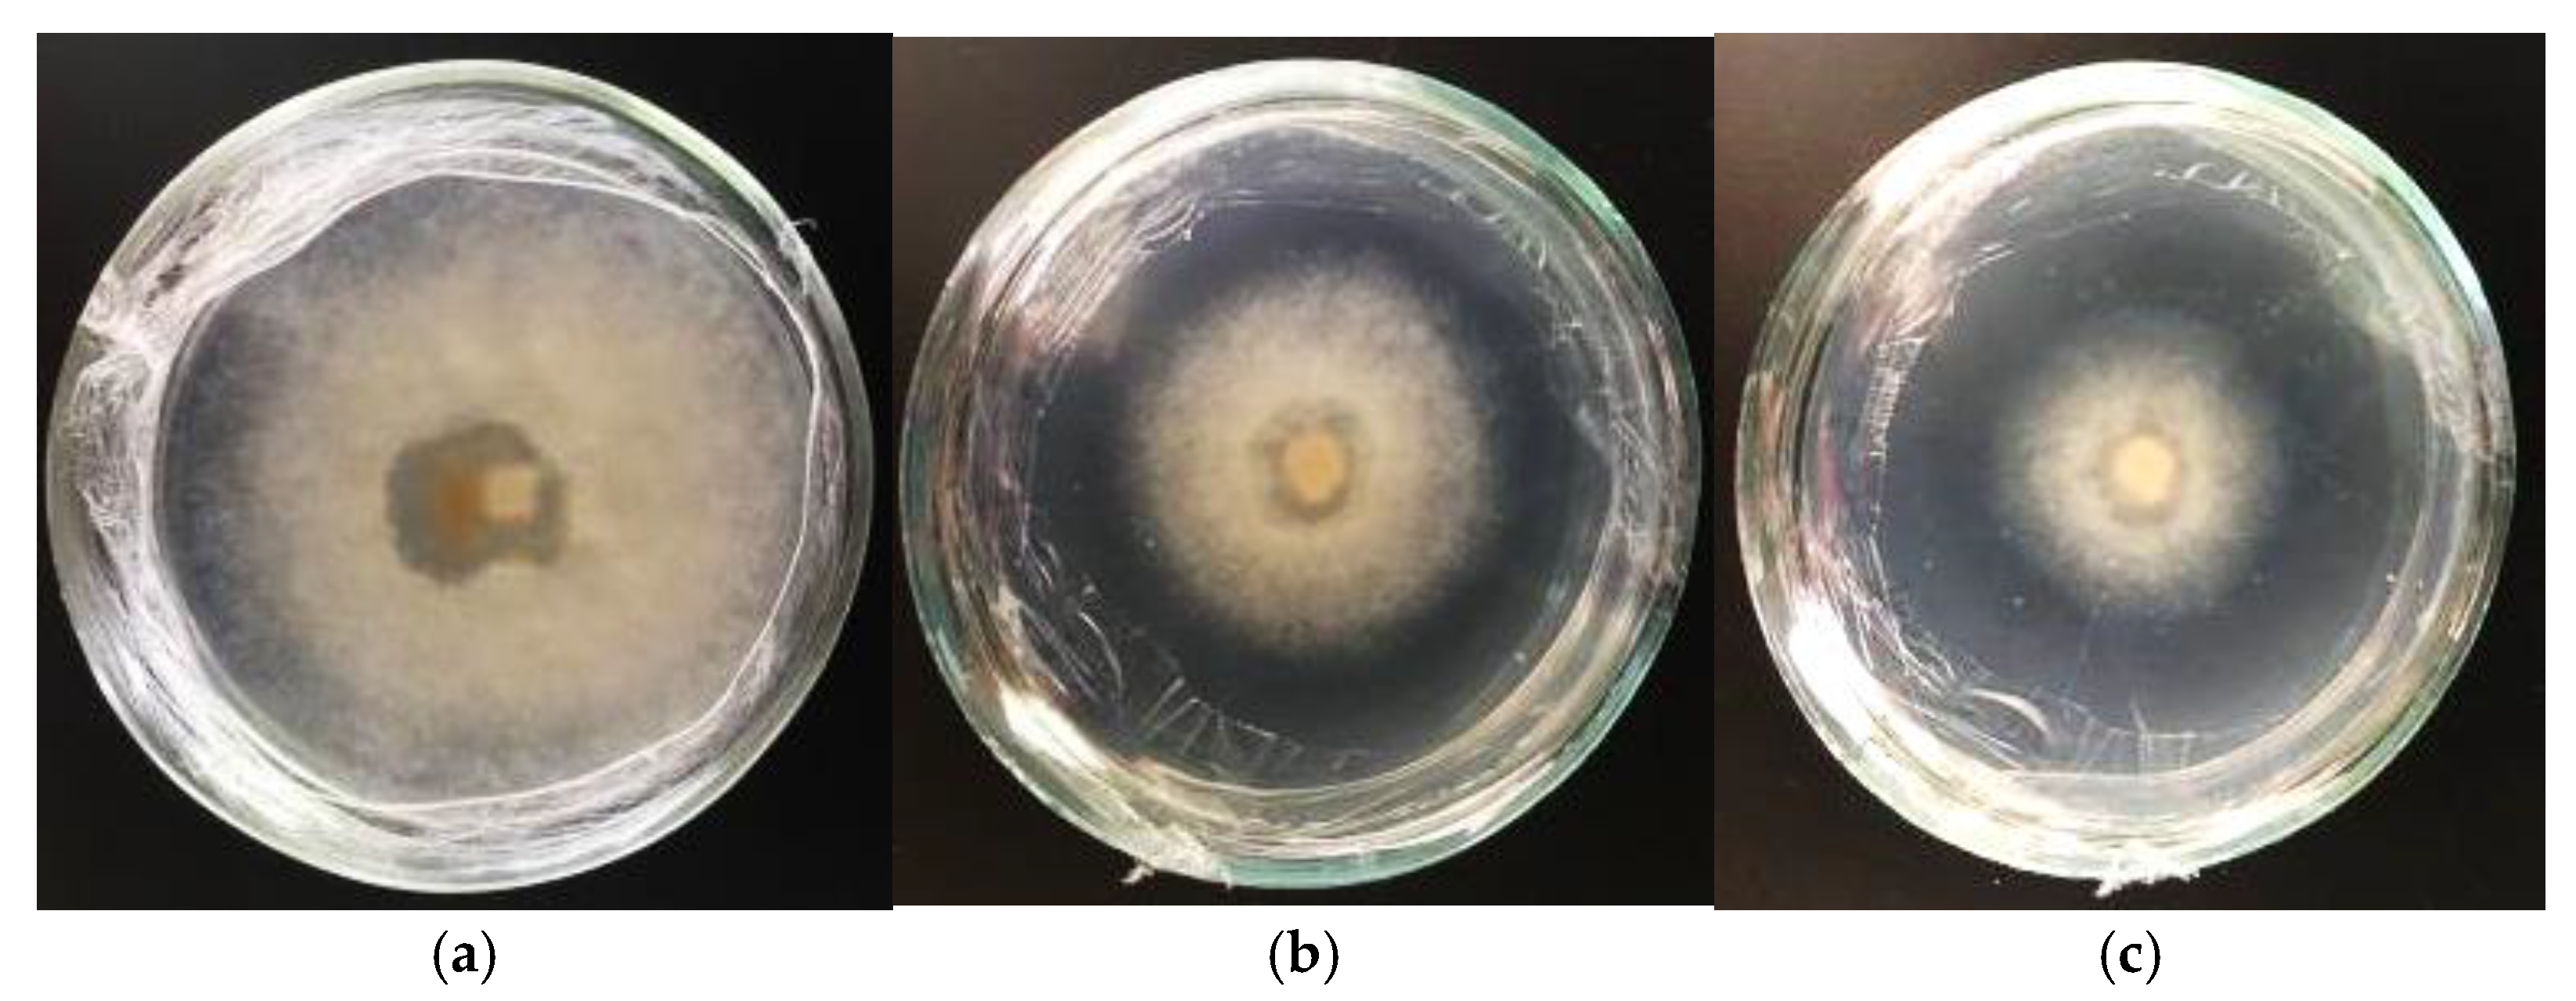
Life 14 01694 g011

Localization of Secondary Metabolites in Relict Gymnosperms of the Genus Sequoia In Vivo and in Cell Cultures In Vitro, and the Biological Activity of Their Extracts
Abstract
1. Introduction
2. Materials and Methods
2.1. The Object of Research
2.2. Obtaining and Cultivating Callus Tissue
2.3. Obtaining and Cultivating Suspension Cell Cultures
2.4. Subculturing Cycle for Suspension Culture
2.5. Localization of Secondary Compounds
2.6. Investigation of the Fungicidal Activity of Extracts
2.7. Cultivation of Mammalian Cells
2.8. Investigation of Extract Cytotoxicity
2.9. Optical Density Measurement
2.10. Statistical Data Processing
3. Results
3.1. Localization of Secondary Metabolites in Intact Sequoia Plants
3.2. Obtaining and Cultivating Callus Tissue
- In all variations, proliferation of callus cells was observed at the sites of cuts and injuries.
- The onset of callus formation was noted between the 14th and 17th days of cultivation in darkness.
- Generally, the callus tissue was of medium density and had a white-yellow color.
- When cultivating primary explants (shoot segments) horizontally in light, callus formation was inhibited, and only in rare cases on days 30 to 40 was dark brown callus with green inclusions observed (Figure 3c,d).
- When cultivating primary explants (shoot segments) vertically in light, callus formation of yellow-green color was observed in the zone of contact between the shoot and the nutrient medium by days 17 to 20 (Figure 5a,b).
3.3. Influence of Light Conditions on Callus Formation in Sequoia sempervirens
3.4. Effects of Vertical Cultivation on Callus Formation in Sequoia sempervirens
3.5. Establishment and Cultivation of Suspension Culture of Sequoia sempervirens
3.6. Localization of Secondary Metabolites in Sequoia In Vitro Cultures
3.7. Suspension Culture of Sequoia and Studies on Fungicidal and Cytotoxic Activity of Extracts
3.7.1. Formation of Secondary Metabolites in Suspension Culture
3.7.2. Investigation of Fungicidal Activity of Extracts
3.7.3. Investigation of Cytotoxic Effects of Extracts
4. Discussion
5. Conclusions
Author Contributions
Funding
Institutional Review Board Statement
Informed Consent Statement
Data Availability Statement
Conflicts of Interest
References
- Chen, S.L.; Yu, H.; Luo, H.M.; Wu, Q.; Li, C.F.; Steinmetz, A. Conservation and sustainable use of medicinal plants: Problems, progress, and prospects. Chin. Med. 2016, 11, 37. [Google Scholar] [CrossRef]
- Khalid, M.; Rahman, S.U.; Liu, X.; Hui, N. Exogenous application of glycine and nitrate on antioxidant and polyphenol metabolism in Brassica campestris spp. Chinensis. J. Plant Nutr. 2023, 46, 2089–2103. [Google Scholar] [CrossRef]
- Yang, Z.Q.; Chen, H.; Tan, J.H.; Xu, H.L.; Jia, J.; Feng, Y.H. Cloning of three genes involved in the flavonoid metabolic pathway and their expression during insect resistance in Pinus massoniana Lamb. Genet. Mol. Res. 2016, 15, 332–343. [Google Scholar] [CrossRef] [PubMed]
- Nielsen, E.; Temporiti, M.E.E.; Cella, R. Improvement of phytochemical production by plant cells and organ culture and by genetic engineering. Plant Cell Rep. 2019, 38, 1199–1215. [Google Scholar] [CrossRef]
- El-Hawary, S.S.; Abd El-Kader, E.M.; Rabeh, M.A.; Abdel Jaleel, G.A.; Arafat, M.A.; Schirmeister, T.; Abdelmohsen, U.R. Eliciting callus culture for production of hepatoprotective flavonoids and phenolics from Sequoia sempervirens (D. Don Endl). Nat. Prod. Res. 2020, 34, 3125–3129. [Google Scholar] [CrossRef] [PubMed]
- Chowdhary, V.; Alooparampil, S.; Pandya, R.V.; Tank, J.G. Physiological function of phenolic compounds in plant defense system. In Phenolic Compounds—Chemistry, Synthesis, Diversity, Non-Conventional Industrial, Pharmaceutical and Therapeutic Applications; IntechOpen: London, UK, 2021. [Google Scholar]
- Roba, K. The role of terpene (secondary metabolite). Nat. Prod. Chem. Res. 2020, 9, 1000p411. [Google Scholar]
- Badria, F.A.; Blumenberg, M. Phenolic Compounds: Chemistry, Synthesis, Diversity, Non-Conventional Industrial, Pharmaceutical and Therapeutic Applications; BoD–Books on Demand: Norderstedt, Germany, 2022. [Google Scholar]
- Kumar, S.; Bhushan, B.; Wakchaure, G.C.; Meena, K.K.; Kumar, M.; Meena, N.L.; Rane, J. Plant phenolics under water-deficit conditions: Biosynthesis, accumulation, and physiological roles in water stress alleviation. Plant Phenolics Sustain. Agric. 2020, 1, 451–465. [Google Scholar]
- Spence, P.; Reed, J.; Osbourn, A. Harnessing plant biosynthesis for the development of next-generation therapeutics. PLoS Biol. 2024, 22, e3002886. [Google Scholar] [CrossRef] [PubMed]
- Biała, W.; Jasiński, M. The phenylpropanoid case–it is transport that matters. Front. Plant Sci. 2018, 9, 1610. [Google Scholar] [CrossRef] [PubMed]
- Ji, W.; Osbourn, A.; Liu, Z. Understanding metabolic diversification in plants: Branchpoints in the evolution of specialized metabolism. Philos. Trans. B 2024, 379, 20230359. [Google Scholar] [CrossRef]
- Marchev, A.S.; Yordanova, Z.P.; Georgiev, M.I. Green (cell) factories for advanced production of plant secondary metabolites. Crit. Rev. Biotechnol. 2020, 40, 443–458. [Google Scholar] [CrossRef]
- Francisco, M.; David, G.; Francisco, M. Notes of Changes in Biodiversity in the Exploited Populations of Cistus Ladanifer L., (Cistaceae) from SW Iberian Peninsula. Biodivers. Online J. 2022, 2, 540. [Google Scholar]
- Tomilova, S.V.; Globa, E.B.; Demidova, E.V.; Nosov, A.M. Secondary metabolism in Taxus spp. plant cell culture in vitro. Russ. J. Plant Physiol. 2023, 70, 23. [Google Scholar] [CrossRef]
- Matsuura, H.N.; Malik, S.; de Costa, F.; Yousefzadi, M.; Mirjalili, M.H.; Arroo, R.; Fett-Neto, A.G. Specialized plant metabolism characteristics and impact on target molecule biotechnological production. Mol. Biotechnol. 2018, 60, 169–183. [Google Scholar] [CrossRef]
- Taha, L.S.; Salama, W.H.; Mazhar, A.A.; Hashish, K.I.; El-Sayed, I.M. A comparative study of biochemical changes on micropropagated Sequoia sempervirens using potassium silicate and silica nanoparticles. J. Pharm. Negat. Results 2022, 13, 2592–2601. [Google Scholar]
- Taha, K.F.; Abd El Shakour, Z.T. Phytochemical Profile of Sequoia Sempervirens Grown in Egypt. Int. J. Pharm. Sci. Res. 2017, 8, 1081–1090. [Google Scholar]
- Sillett, S.C.; Van Pelt, R.; Carroll, A.L.; Kramer, R.D.; Ambrose, A.R.; Trask, D.A. How do tree structure and old age affect growth potential of California redwoods? Ecol. Monogr. 2015, 85, 181–212. [Google Scholar] [CrossRef]
- Disney, M.; Burt, A.; Wilkes, P.; Armston, J.; Duncanson, L. New 3D measurements of large redwood trees for biomass and structure. Sci. Rep. 2020, 10, 16721. [Google Scholar] [CrossRef]
- Davies, N.T.; Wu, H.F.; Altaner, C.M. The chemistry and bioactivity of various heartwood extracts from redwood (Sequoia sempervirens) against two species of fungi. N. Z. J. For. Sci. 2014, 44, 17. [Google Scholar] [CrossRef]
- Breidenbach, N.; Gailing, O.; Krutovsky, K.V. Assignment of frost tolerant coast redwood trees of unknown origin to populations within their natural range using nuclear and chloroplast microsatellite genetic markers. bioRxiv 2019. [Google Scholar] [CrossRef]
- Šijačić-Nikolić, M.; Nonić, M.; Lalović, V.; Milovanović, J.; Nedeljković, J.; Nonić, D. Conservation of forest genetic resources: Key stakeholders’ attitudes in forestry and nature protection. Genetika 2017, 49, 875–890. [Google Scholar] [CrossRef]
- Youssef, N.M.; Taha, L.S.; El-Khalek, S.N.A. Antioxidant activity, active compounds and oil characterization of in vitro Sequoia sempervirens cultures. Asian J. Plant Sci. 2021, 20, 673–683. [Google Scholar] [CrossRef]
- Marzouk, M.; Farid, M.M.; Fathy, H.; Sokkar, N. GC/MS Analysis and Secondary Metabolites Determination with Antioxidant and Anticancer Evaluation of Sequoia sempervirens (D. Don) Endl. through Micropropagated Cultures. Egypt. J. Chem. 2023, 66, 211–223. [Google Scholar] [CrossRef]
- Murashige, T.; Skoog, F. A revised medium for rapid growth and bio assays with tobacco tissue cultures. Physiol. Plantarum. 1962, 15, 473–497. [Google Scholar] [CrossRef]
- McCown, B.H. Woody Plant Medium (WPM)-a mineral nutrient formulation for microculture for woody plant species. Hort. Sci. 1981, 16, 453. [Google Scholar]
- Zaitseva, S.M.; Kalashnikova, E.A.; Kirakosyan, R.N.; Balakina, A.A. In vitro cell cultures of Ginkgo biloba L., introduced in the moscow region are promising sources of substances with high biological activity. Probl. Biol. Med. Pharm. Chem. 2024, 27, 67–78. [Google Scholar] [CrossRef]
- Yadav, V.; Arif, N.; Singh, V.P.; Guerriero, G.; Berni, R.; Shinde, S.; Tripathi, D.K. Histochemical techniques in plant science: More than meets the eye. Plant Cell Physiol. 2021, 62, 1509–1527. [Google Scholar] [CrossRef] [PubMed]
- Badria, F.A.; Aboelmaaty, W.S. Plant Histochemistry: A versatile and indispensible tool in localization of gene expression, enzymes, cytokines, secondary metabolites and detection of plants infection and pollution. Acta Sci. Pharm. Sci. 2019, 3, 88–100. [Google Scholar] [CrossRef]
- OFS.1.5.1.0002.15; «Travy» Gosudarstvennaya Farmakopeya RF. 13-e izdanie, t. 2. Federal State Budgetary Institution: Moscow, Russia, 2015.
- Maharaj, A.; Naidoo, Y.; Dewir, Y.; Mujib, A. Seasonal variations in micromorphology, ultrastructure, and histochemistry of mango (Mangifera indica L.) leaves. Appl. Ecol. Environ. Res. 2024, 22, 4309–4328. [Google Scholar] [CrossRef]
- Babushkina, E.V.; Smirnov, P.D.; Kostina, O.V.; Muravnik, L.E.; Razarenova, K.N. Gistohimiya trihom oficinal’nyh predstavitelej semejstva Lamiaceae. Med. al’Manah 2017, 3, 48. [Google Scholar]
- Kalashnikova, E.A.; Zajceva, S.M.; Kirakosyan, R.N. Citotoksichnost’ i fungicidnaya aktivnost’ ekstraktov, poluchennyh iz rastenij ashvagandy i astragala v usloviyah in vitro. Aktual’nye Vopr. Vet. Biol. 2019, 2, 57–63. [Google Scholar]
- Tashmatova, L.V.; Macneva, O.V.; SHahov, V.V.; Hromova, T.M. Osobennosti pervogo etapa klonal’nogo mikrorazmnozheniya immunnyh sortov yabloni. Sovrem. Sadovod.—Contemp. Hortic. 2018, 3, 114–121. [Google Scholar]
- Van Pelt, R.; Sillett, S.C.; Kruse, W.A.; Freund, J.A.; Kramer, R.D. Emergent crowns and light-use complementarity lead to global maximum biomass and leaf area in Sequoia sempervirens forests. For. Ecol. Manag. 2016, 375, 279–308. [Google Scholar] [CrossRef]
- Szymańska, R.; Ślesak, I.; Orzechowska, A.; Kruk, J. Physiological and biochemical responses to high light and temperature stress in plants. Environ. Exp. Bot. 2017, 139, 165–177. [Google Scholar] [CrossRef]
- Conéjéro, G.; Noirot, M.; Talamond, P.; Verdeil, J.L. Spectral analysis combined with advanced linear unmixing allows for histolocalization of phenolics in leaves of coffee trees. Front. Plant Sci. 2014, 5, 39. [Google Scholar] [CrossRef]
- Kirakosyan, R.N.; Golivanov, Y.Y.; Trukhachev, V.I.; Zaitseva, S.M.; Khaliluev, M.R.; Baranova, E.N.; Kalashnikova, E.A. Colleter Formation on the Leaves of Sweet Potato Microclones (Ipomoea batatas L.) under In Vitro Conditions. Russ. J. Plant Physiol. 2023, 70, 115. [Google Scholar] [CrossRef]
- Wang, Y.; Huang, C.; Zeng, W.; Zhang, T.; Zhong, C.; Deng, S.; Tang, T. Epigenetic and transcriptional responses underlying mangrove adaptation to UV-B. Iscience 2021, 24, 103148. [Google Scholar] [CrossRef] [PubMed]
- Barros, J.; Serk, H.; Granlund, I.; Pesquet, E. The cell biology of lignification in higher plants. Ann. Bot. 2015, 115, 1053–1074. [Google Scholar] [CrossRef] [PubMed]
- Mai, M.H.; Gao, C.; Bork, P.A.; Holbrook, N.M.; Schulz, A.; Bohr, T. Relieving the transfusion tissue traffic jam: A network model of radial transport in conifer needles. New Phytol. 2024, 244, 2183–2196. [Google Scholar] [CrossRef]
- Yang, C.; Fan, F.; Xu, G.; Ding, G. Development, differentiation, and material distribution of secondary phloem in Pinus massoniana. J. For. Res. 2023, 34, 1915–1926. [Google Scholar] [CrossRef]
- Lourenço, A.; Rencoret, J.; Chemetova, C.; Gominho, J.; Gutierrez, A.; Del Rio, J.C.; Pereira, H. Lignin composition and structure differs between xylem, phloem and phellem in Quercus suber L. Front. Plant Sci. 2016, 7, 1612. [Google Scholar] [CrossRef]
- Choudhary, S.B.; Chowdhury, I.; Singh, R.K.; Pandey, S.P.; Sharma, H.K.; Anil Kumar, A.; Jambhulkar, S.J. Morphological, histobiochemical and molecular characterisation of low lignin phloem fibre (llpf) mutant of dark jute (Corchorus olitorius L.). Appl. Biochem. Biotechnol. 2017, 183, 980–992. [Google Scholar] [CrossRef] [PubMed]
- Cesarino, I. Structural features and regulation of lignin deposited upon biotic and abiotic stresses. Curr. Opin. Biotechnol. 2019, 56, 209–214. [Google Scholar] [CrossRef]
- Winkel, B.S. The subtleties of subcellular distribution: Pointing the way to underexplored functions for flavonoid enzymes and endproducts. Recent Adv. Polyphen. Res. 2019, 6, 89–107. [Google Scholar]
- Feucht, W.; Schmid, M.; Treutter, D. DNA and flavonoids leach out from active nuclei of Taxus and Tsuga after extreme climate stresses. Plants 2015, 4, 710–727. [Google Scholar] [CrossRef] [PubMed]
- Zhou, Z.; Schenke, D.; Miao, Y.; Cai, D. Investigation of the crosstalk between the flg22 and the UV-B-induced flavonol pathway in Arabidopsis thaliana seedlings. Plant Cell Environ. 2017, 40, 453–458. [Google Scholar] [CrossRef] [PubMed]
- Zhang, F.; Yang, C.; Guo, H.; Li, Y.; Shen, S.; Zhou, Q.; Liu, Y. Dissecting the genetic basis of UV-B responsive metabolites in rice. Genome Biol. 2024, 25, 234. [Google Scholar] [CrossRef] [PubMed]
- Potkay, A.; Hölttä, T.; Trugman, A.T.; Fan, Y. Turgor-limited predictions of tree growth, height and metabolic scaling over tree lifespans. Tree Physiol. 2022, 42, 229–252. [Google Scholar] [CrossRef] [PubMed]
- Feucht, W.; Schmid, M.; Treutter, D. Acclimation changes of flavonoids in needles of conifers during heat and drought stress 2015. Climate 2016, 4, 35. [Google Scholar] [CrossRef]
- Bouche, P.S.; Larter, M.; Domec, J.C.; Burlett, R.; Gasson, P.; Jansen, S.; Delzon, S. A broad survey of hydraulic and mechanical safety in the xylem of conifers. J. Exp. Bot. 2014, 65, 4419–4431. [Google Scholar] [CrossRef] [PubMed]
- Stegner, M.; Buchner, O.; Geßlbauer, M.; Lindner, J.; Flörl, A.; Xiao, N.; Neuner, G. Frozen mountain pine needles: The endodermis discriminates between the ice-containing central tissue and the ice-free fully functional mesophyll. Physiol. Plant. 2023, 175, e13865. [Google Scholar] [CrossRef] [PubMed]
- Yu, Y.; Kang, H.; Wang, H.; Wang, Y.; Tang, Y. The leaf-scale mass-based photosynthetic optimization model better predicts photosynthetic acclimation than the area-based. AoB Plants 2024, 16, plae044. [Google Scholar] [CrossRef]
- Coble, A.P.; Fogel, M.L.; Parker, G.G. Canopy gradients in leaf functional traits for species that differ in growth strategies and shade tolerance. Tree Physiol. 2017, 37, 1415–1425. [Google Scholar] [CrossRef]
- Ambrose, A.R.; Baxter, W.L.; Wong, C.S.; Burgess, S.S.; Williams, C.B.; Næsborg, R.R.; Dawson, T.E. Hydraulic constraints modify optimal photosynthetic profiles in giant sequoia trees. Oecologia 2016, 182, 713–730. [Google Scholar] [CrossRef] [PubMed]
- Wen, H.; Deng, X.; Zhang, Y.; Wei, X.; Wang, G.J.; Zhou, B.; Zhu, N.H. Cunninghamia lanceolata variant with red-heart wood: A mini-review. Dendrobiology 2018, 79, 156–167. [Google Scholar] [CrossRef]
- Morrison, W.M.; Armstrong, A.D.; Webb, L.A.; Dagley, C.M.; Cahill, K.G.; Berrill, J.P. Performance and genetic analysis of coast redwood cultivars for afforestation of converted grassland in California. New Forests 2022, 53, 1–16. [Google Scholar]
- McDonnell, H.; Filipescu, C.N.; Stirling, R.; Barbeito, I. Radial distribution of heartwood extractives in second-growth western redcedar. Can. J. For. Res. 2024, 54, 1048–1056. [Google Scholar] [CrossRef]
- Cui, L.; Li, M.; Zhang, X.; Guo, Z.; Li, K.; Shi, Y.; Guo, H. Enhanced UV-B Radiation in Potato Stems and Leaves Promotes the Accumulation of Anthocyanins in Tubers. Curr. Issues Mol. Biol. 2023, 45, 9943–9960. [Google Scholar] [CrossRef] [PubMed]
- Cetin, E.S. Induction of secondary metabolite production by UV-C radiation in Vitis vinifera L. Öküzgözü callus cultures. Biol. Res. 2014, 47, 37. [Google Scholar] [CrossRef] [PubMed]
- Speeckaert, N.; El Jaziri, M.; Baucher, M.; Behr, M. UGT72, a major glycosyltransferase family for flavonoid and monolignol homeostasis in plants. Biology 2022, 11, 441. [Google Scholar] [CrossRef]
- Pugacheva, A.M.; Bikmetova, K.R.; Smirnova, Y.S. Sorbenty fenolov kak komponenty pitatel’noj sredy v mikroklonal’nom razmnozhenii rastenij. Prir. Sist. Resur. 2021, 11, 39–48. [Google Scholar]
- Hao, D.C. Taxaceae and Cephalotaxaceae: Biodiversity, Chemodiversity, and Pharmacotherapy; Academic Press: Cambridge, MA, USA, 2021. [Google Scholar]
- Zaitseva, S.M.; Kalashnikova, E.A.; Kirakosyan, R.N. The influence of endogenous polyphenols, photoperiod and mineral composition of the nutrient medium on the formation of callus tissue of relic gymnosperms Sequoia sempervirens (D. Don) Endl. Probl. Biol. Med. Pharm. Chem. 2023, 26, 46–57. [Google Scholar] [CrossRef]
- Ahanger, M.A.; Bhat, J.A.; Siddiqui, M.H.; Rinklebe, J.; Ahmad, P. Integration of silicon and secondary metabolites in plants: A significant association in stress tolerance. J. Exp. Bot. 2020, 71, 6758–6774. [Google Scholar] [CrossRef]
- González, M.A. Aromatic abietane diterpenoids: Their biological activity and synthesis. Nat. Product. Rep. 2015, 32, 684–704. [Google Scholar] [CrossRef] [PubMed]
- Jan, R.; Asaf, S.; Numan, M.; Lubna Kim, K.M. Plant secondary metabolite biosynthesis and transcriptional regulation in response to biotic and abiotic stress conditions. Agronomy 2021, 11, 968. [Google Scholar] [CrossRef]
- Blaschek, L.; Pesquet, E. Phenoloxidases in plants—How structural diversity enables functional specificity. Front. Plant Sci. 2021, 12, 754601. [Google Scholar] [CrossRef]

| Indicators | Callus | |
|---|---|---|
| MS | WPM | |
| Diameter growth (cm) | 0.92 | 1.05 |
| Growth index (I) | 1.46 | 1.53 |
| Specific growth rate (μ) | 0.030 | 0.031 |
| Concentration of Extract, mg/L | ||||||||||
|---|---|---|---|---|---|---|---|---|---|---|
| K | 50 | 100 | 150 | 200 | 250 | 300 | 350 | 400 | 450 | 500 |
| Extracts from the shoots of Sequoia during the winter growing period | ||||||||||
| 9.0 ± 0.4 | 9.0 ± 0.4 | 9.0 ± 0.4 | 8.7 ± 0.4 | 8.4 ± 0.3 | 8.3 ± 0.3 | 7.7 ± 0.3 | 6.2 ± 0.3 | 4.8 ± 0.3 | 4.3 ± 0.2 | 3.7 ± 0.2 |
| Extracts from callus tissue | ||||||||||
| 9.0 ± 0.4 | 9.0 ± 0.4 | 9.0 ± 0.4 | 9.0 ± 0.4 | 9.0 ± 0.3 | 8.8 ± 0.3 | 8.6 ± 0.3 | 7.5 ± 0.3 | 6.9 ± 0.3 | 6.1 ± 0.3 | 5.8 ± 0.3 |
Disclaimer/Publisher’s Note: The statements, opinions and data contained in all publications are solely those of the individual author(s) and contributor(s) and not of MDPI and/or the editor(s). MDPI and/or the editor(s) disclaim responsibility for any injury to people or property resulting from any ideas, methods, instructions or products referred to in the content. |
© 2024 by the authors. Licensee MDPI, Basel, Switzerland. This article is an open access article distributed under the terms and conditions of the Creative Commons Attribution (CC BY) license (https://creativecommons.org/licenses/by/4.0/).
Share and Cite
Kirakosyan, R.N.; Kalasnikova, E.A.; Bolotina, E.A.; Saleh, A.; Balakina, A.A.; Zaytseva, S.M. Localization of Secondary Metabolites in Relict Gymnosperms of the Genus Sequoia In Vivo and in Cell Cultures In Vitro, and the Biological Activity of Their Extracts. Life 2024, 14, 1694. https://doi.org/10.3390/life14121694
Kirakosyan RN, Kalasnikova EA, Bolotina EA, Saleh A, Balakina AA, Zaytseva SM. Localization of Secondary Metabolites in Relict Gymnosperms of the Genus Sequoia In Vivo and in Cell Cultures In Vitro, and the Biological Activity of Their Extracts. Life. 2024; 14(12):1694. https://doi.org/10.3390/life14121694
Chicago/Turabian StyleKirakosyan, Rima N., Elena A. Kalasnikova, Elizaveta A. Bolotina, Abdulrahman Saleh, Anastasiya A. Balakina, and Svetlana M. Zaytseva. 2024. "Localization of Secondary Metabolites in Relict Gymnosperms of the Genus Sequoia In Vivo and in Cell Cultures In Vitro, and the Biological Activity of Their Extracts" Life 14, no. 12: 1694. https://doi.org/10.3390/life14121694
APA StyleKirakosyan, R. N., Kalasnikova, E. A., Bolotina, E. A., Saleh, A., Balakina, A. A., & Zaytseva, S. M. (2024). Localization of Secondary Metabolites in Relict Gymnosperms of the Genus Sequoia In Vivo and in Cell Cultures In Vitro, and the Biological Activity of Their Extracts. Life, 14(12), 1694. https://doi.org/10.3390/life14121694

